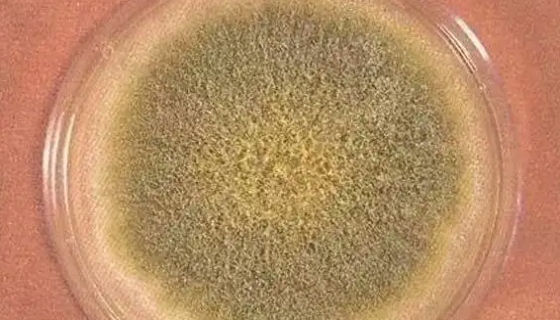
黄曲霉的检验检疫要求与方法及检测方法的分析！

凝结芽孢杆菌的性质特点与药学研究及药理作用!
凝结芽孢杆菌(Bacillus coagulans),革兰阳...

白色念珠菌致病机制的毒力因素及检查与培养!
白色念珠菌,广泛存在于自然界,也存在于正常人口腔,上呼吸道,...

脑膜炎奈瑟菌的生物学性状及致病性与免疫性!
脑膜炎奈瑟菌(N. meningitidis)简称为脑膜炎球...

猪细小病毒的临床症状及防控与治疗!
猪细小病毒是Parvovirus属的微生物。中监所,PPV7...

小鼠脑微血管内皮细胞的体外培养与相关研究!
脑微血管内皮细胞是血脑屏障的主要组成成分,能够限制可溶性物质...

藤黄微球菌——四联球菌的典型代表
藤黄微球菌是微球菌科(Micrococcus)的细菌,其革兰...
黄曲霉的检验检疫要求与方法及检测方法的分析!
黄曲霉,半知菌类,一种常见腐生真菌。多见于发霉的粮食、粮制品...

肺炎克雷伯氏菌毒力因子的研究进展!
肺炎克雷伯氏菌(Klebsiella pneumoniae)...

原代细胞——人脑血管周细胞的背景与应用!
人脑血管周细胞提取于人脑组织,原代冻存,此细胞通过对alph...